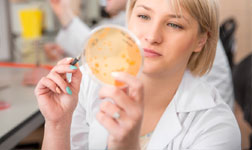
Wydział Technologiczno-Przyrodniczy UR

FAQ - najczęściej zadawane pytania:
Czy istnieje granica wieku, która ogranicza możliwość podjęcia studiów w systemie stacjonarnym?+
Pytanie oczekuje na odpowiedź ze strony uczelni.
Jakie dokumenty należy dostarczyć po zakwalifikowaniu się na studia stacjonarne I stopnia?+
Pytanie oczekuje na odpowiedź ze strony uczelni.
W jaki sposób i gdzie mogę dostarczyć dokumenty na Uczelnię?+
Pytanie oczekuje na odpowiedź ze strony uczelni.
Czy dokumenty muszę składać osobiście?+
Pytanie oczekuje na odpowiedź ze strony uczelni.
Jakie dokumenty muszą być poświadczone notarialnie?+
Pytanie oczekuje na odpowiedź ze strony uczelni.
Czy dokumenty mogą zostać złożone w imieniu kandydata przez upoważnioną osobę?+
Pytanie oczekuje na odpowiedź ze strony uczelni.
Czy kandydaci, którzy znajdują się na liście rezerwowej, też muszą składać dokumenty?+
Pytanie oczekuje na odpowiedź ze strony uczelni.
Czy wyniki matur należy wpisywać samodzielnie?+
Pytanie oczekuje na odpowiedź ze strony uczelni.
Czy w procedurze rekrutacyjnej brana jest pod uwagę część ustna egzaminu maturalnego?+
Pytanie oczekuje na odpowiedź ze strony uczelni.
Jak wygląda procedura przyjęć dla kandydatów będących laureatami bądź finalistami olimpiad przedmiotowych?+
Pytanie oczekuje na odpowiedź ze strony uczelni.
Na jakiej zasadzie ustalane są progi punktowe dla poszczególnych kierunków?+
Pytanie oczekuje na odpowiedź ze strony uczelni.
W jaki sposób zostanę poinformowany o zakwalifikowaniu do przyjęcia / przyjęciu na studia?+
Pytanie oczekuje na odpowiedź ze strony uczelni.
Czy w dostaniu się na studia ma znaczenie kolejność zgłoszeń?+
Pytanie oczekuje na odpowiedź ze strony uczelni.
Czy zakwalifikowany do przyjęcia oznacza przyjęty na studia?+
Pytanie oczekuje na odpowiedź ze strony uczelni.
Czy pełna rejestracja elektroniczna wraz z uiszczoną opłatą rekrutacyjną daje podstawę do rozpatrywania wniosku o przyjęcie na studia?+
Pytanie oczekuje na odpowiedź ze strony uczelni.
W jaki sposób można dokonać opłaty rekrutacyjnej?+
Pytanie oczekuje na odpowiedź ze strony uczelni.
Co wpisać w tytule przelewu?+
Pytanie oczekuje na odpowiedź ze strony uczelni.
W jakim terminie należy dokonać opłaty rekrutacyjnej?+
Pytanie oczekuje na odpowiedź ze strony uczelni.
Co się stanie, jeśli nie wniosę opłaty rekrutacyjnej w wymaganym terminie (nie będzie ona zaksięgowana w wymaganym terminie)?+
Pytanie oczekuje na odpowiedź ze strony uczelni.
Czy przelew muszę zrobić z mojego konta, czy może go zrobić za mnie np. mama?+
Pytanie oczekuje na odpowiedź ze strony uczelni.
Jakie przedmioty brane są pod uwagę w procesie kwalifikacyjnym?+
Pytanie oczekuje na odpowiedź ze strony uczelni.
Czy brak na maturze jakiegoś z punktowanych w rekrutacji przedmiotów, dyskwalifikuje mnie z ubiegania się o przyjęcie na wybrany kierunek studiów?+
Pytanie oczekuje na odpowiedź ze strony uczelni.
O przyjęcie na ile kierunków studiów mogę się ubiegać?+
Pytanie oczekuje na odpowiedź ze strony uczelni.
W jaki sposób dokonywana jest procedura przeniesienia?+
Pytanie oczekuje na odpowiedź ze strony uczelni.
Do kiedy i w jakim formacie muszę zamieścić zdjęcie elektroniczne w formularzu rejestracyjnym?+
Pytanie oczekuje na odpowiedź ze strony uczelni.
Wasze pytania:
ćzy Uniwersytet kształci pod kątem Międzynarodowych Targów Gospodarczych Krajów Viacarpatia ViaBaltica S 19 KrosnoRzeszów?+
Pytanie od: rych
Pytanie oczekuje na odpowiedź ze strony uczelni.
Czy w czasie studiów biologicznych na UR jest możliwość kursu pedagogicznego aby później można było uczyć biologii w szkole podstawowej lub średniej?+
Pytanie od: Maturzystka
Pytanie oczekuje na odpowiedź ze strony uczelni.
Dzień dobry. Mam takie pytanie czy ma uniwersytet w sobie system nauki na weekendach ( zaoczny )?+
Pytanie od: Pytanie co do nauki w Uniwersytecie Rzeszowskim.
Pytanie oczekuje na odpowiedź ze strony uczelni.
Dzień dobry. W roku 2001 zapisałam się na studia ekonomiczne w Rzeszowie,ale ich nie zaczęłam. Zostawiłam mój dyplom którego teraz potrzebuję. Nie pamiętam dobrze jak ma na imię i który to był uniwersytet,pamiętam tylko ze został założony w 2001 roku,wydział ekonomiczny.Moje imię to Anna Maria Czycz,urodzona 3 maja1980.Adres:Nowa Wieś 39,37-740 Bircza+
Pytanie od: Anna Maria Czycz
Pytanie oczekuje na odpowiedź ze strony uczelni.

 al. Rejtana 16c,
al. Rejtana 16c, tel. +48 17 872 10 00
tel. +48 17 872 10 00